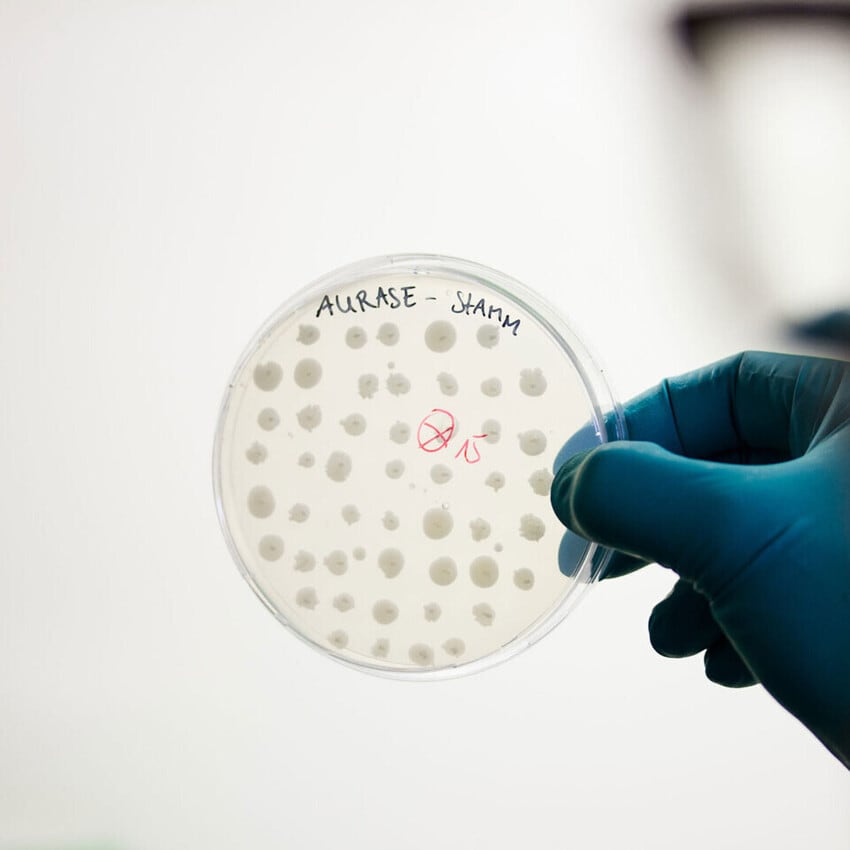
Private Equity Sale

Advantages
Relative simplicity and non-disruption: As opposed to other types of sale involving assets or capital, an equity sale revolves around the transfer of shares. The daily operations, employees, customers, and other stakeholders can remain unchanged as it is the ownership structure that undergoes significant alteration.
Owner remains in role: Similar to the non-disruptive aspect of a private equity deal the founder or owner can remain in their role and maintain strategic or operational control. A successful PE sale constitutes the backing of the management team’s vision and plan for the business.
Grow board expertise: The sale of equity can bring on new stakeholders, who can provide knowledge, experience, and opportunities. This can unlock new potential for a business, such as specialist sector expertise or access to new networks and channels to further develop your contacts.
Access to capital: In exchange for a portion of shares comes an often significant amount of capital, which can be used for a variety of purposes; investing in equipment, geographic expansion or other forms of growth and development.